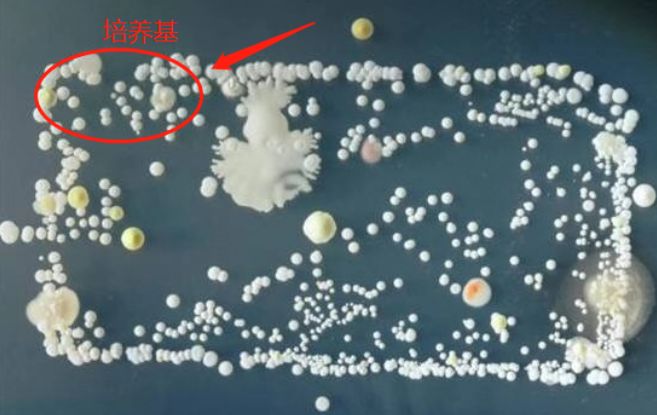
你们的痘痘最后都是怎么完全好的？反正我是用了这个方法才好的
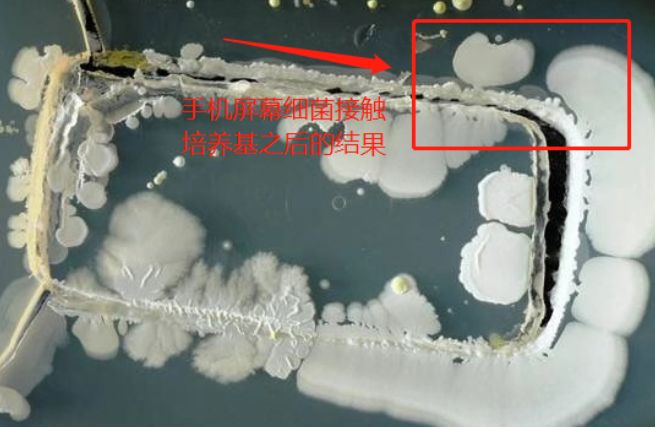
你们的痘痘最后都是怎么完全好的？反正我是用了这个方法才好的

Hi,大家好,我是写啥啥不见的“露西”小姐姐。

哎,又要来说我的烂脸故事爆烂脸照了。

我呢,是作息不正+饮食不正+护肤不正+tuo脸毛触发烂脸开关导致饮食作息和护肤不当积累的伤害一下爆发,欧克,成功烂脸!对烂脸故事我主页之前有写过相关文章,感兴趣就去瞅一眼哈。
这里不重复了哈,大家都挺忙的,我就直接讲痘痘了。因为我自己在治疗过程中,有用了其他产品,以防广告嫌疑,我就用客观科学的方式讲“如何祛痘”照骗还是要放几张的~给你们加油打气~你们也要相信你们自己的脸一定会变成“去壳鸡蛋肌”的!
你们看,我之前长这样!!!

你们再看,我现在长这样!!!欧克,照骗走起~~


来
配合下

先别着急怼我哈,我老实交代,以上除了1跟2是素颜,3跟4都有加滤镜...而且4还化了个妆...

这不都是为给你们加油打气才发的照pian嘛。。。看完照片的同学都来心信心了吧!OK,我听见了!信心十足!我们可以开始治疗可恶的痘痘君了。

开讲之前先提醒下同学们,,,
不要→心急因为会→乱投医然后你可能比较幸运→投到好医,成功治好痘痘(这种概率可能是%0.00001吧!)正常情况下是:有一半人→没有投错也没有投到好的(但是依然是浪费了时间金钱精力,即使没有导致你的痘痘直接加重,但是痘痘修复时间也拖延了,间接的等于加重痘痘)另一半人→投错医(浪费了时间金钱精力,直接性导致痘痘的加重,而造成后面的创伤留下痘疤/痘坑,才是最“恐怖”的)我个人经历非常真实了,说下我的乱投医经历。。。1.某shi王祛痘膏,没用,完全没用,对那种脸上不长痘痘偶尔起一两颗痘痘安抚下去是欧克的,但是烂脸千万不要靠她,我买回来涂了三天,一点效果没见到,扔在冰箱里面了。

以防被怼,说一下这个药膏的成分:主要成分皮考布洛芬+异丙基甲基苯酚。皮考布洛芬属于外用的额消炎药、可以抗炎、镇痛,而异丙基甲基苯酚有抗菌作用(注意,是抗菌不是杀菌)所以对于炎症性痘痘还是能起到效果的。什么去粉刺啊痘印啊别提了,没用。
2.某修正祛痘套装,有的人说有用,但我用完了一个套装。我朋友说:哇,xxx 你的痘痘越来越严重了也,好害怕啊会不会传染!(好叭!)

然后因为睡眠不好,为了让自己早点入睡,听人家说喝牛奶有助于睡眠,我还买了一大瓶蓝胖子奶粉,喝了一年喝光光...(真的不好喝,没味道,不知道是什么力量让我坚持喝完它的...)

然后后来知道喝奶致痘???
再看见某书上的牛奶炖桃胶,相当于10片面膜,喝一个月就能变牛奶肌,牛奶肌?一顿马力加速去超市买回来各种原材料,每天起早贪黑的煮。。。然后后来知道桃胶是寒性食物??

折腾了大半年,不行了,我去找个医生看吧,可能我跟大多数痘肌患者不一样(也可能是地域不同的原因,我们这边很少会去医院,除非是什么大病级别的。。)并且我自己意识里不觉得这是一种病,后来没办法,实在害怕,去医院了,我的*疮痤**程度太轻了,就1-2到级,然后医生蜀黍给我以“多喝热水”的方式治疗并开了支克林霉素早晚涂抹,就叫我回家了。。好叭!然后药膏我也没用。。折腾了大半年,既然城市没有我容(治)身(不)之(好)地(痘痘),那我就回农村混吧,看了个有名的中医,我以为中医蜀黍不会像西医蜀黍那样敷衍我,果然,中医蜀黍说我这个是青春痘时间过了就好了 ,早睡,多喝水,喝水,水。。。

国际惯例讲故事完毕,同学们,好好治痘了!!!
此文分2部分:一、祛痘一条龙二、反复长痘的因素(附对应解决方法)小啰嗦小科普是少不了滴,祛痘精华都在这里面,自行翻重点昂,都是看完就可以实操滴东西,赶紧跟我们的痘痘君 say goodbey~
一、祛痘一条龙
1.痘痘分为:无炎症痘痘-黑头/闭口、炎症痘痘-丘疹/脓疱/囊肿结节。
2.无炎症痘痘,粉刺-黑头/闭口:主要跟你的油脂分泌程度和毛囊角化异常有关。当皮脂腺分泌过于旺盛,而堵塞住了毛囊出口(也就是毛孔知道吧!不知道要问!)但是,此时此刻的毛囊并不知情,继续它自己的新陈代谢(皮肤每时每刻都在新陈代谢)这时候,脱落的废旧表皮细胞也会跟这些油脂混合在一起形成角栓,堵塞住我们的毛孔啊。有的毛囊呢比较深,够不到氧气,就变成了一个闭口,有的毛囊够着氧气就会变成黑头,因为氧气中的灰尘垃圾都会掉落在堵塞的毛囊上,所以就有了你们看到的黑头。这里帮同学们捋一下哦,黑头和闭口都统称为【粉刺】所以,黑头因为是开口的,所以叫开口粉刺,而闭口就是闭口粉刺。都属于粉刺。不要再傻傻分不清~乱搞啦!对于闭口,你日常的挤压是挤不出来的,我上面已经说到了它毛囊比较深,一不小心还可能引发炎症。不要等到脸上坑坑洼洼,才明白科学护肤不要手贱有多重要...怎么办啊!肯定是保证日常清洁护肤控油,避免加重油脂分泌的外力因素影响,控制雄激素水平把他们干掉啊!答案在这:【如何去除鼻子上的黑头?】【如何去除闭口?】
但素,还有个问题,我们的皮脂腺无法断!根!意思就是黑头还是会不断长出来,肿么办!
日常护肤加入控油成分可以“有效的减少黑头产生”要知足哦(后面会详细说明)不要跟我说断根这种东西,这是不可能滴,这辈子都不可能。
3.炎症痘痘-丘疹:发炎了啊!天!细菌...你给我出来!这个跟我们皮肤上可爱的微生物(细菌)绝对是脱不了关系的,主要是因为上面的闭口粉刺↑在毛囊堵塞的久了,本身闭口粉刺是隔离了氧气的,没有氧气细菌就容易皮,一皮炎症就来了(所以,闭口粉刺极易发生成炎症痘痘,黑头一般不会)简单说,氧气就属于管着细菌微生物的警察,闭口粉刺把氧气隔开了,里面的细菌就各种嗨皮,毛囊受不了,就会叫一帮“炎症兄弟”来打败细菌,然后毛囊就发炎了。怎么办啊!肯定是保证日常清洁护肤控油,避免加重油脂分泌的外力因素影响,并消除炎症杀死我们的细菌啊!
4.炎症痘痘-脓疱:就是上面的丘疹痘痘加重来的,打它!脓疱的出现就是上面的丘疹痘痘没哟及时处理,细菌受感染而化脓(这里啰嗦一句:即使是一颗小小小的痘痘出现了就马上消灭,痘痘不会自己扁!只会越来越严重!)
手贱*党**星人请向我这边看齐:很多同学跟痘痘君打战打久了,手就痒痒了。看着蠢蠢欲动快要自己爆发的痘痘总是忍不住去触摸(挤)它,挤的那一瞬间有莫名的快感,你们也以为清理(挤)出来脓物,痘痘就要好了。关键是你正确“挤”痘了吗?啊?你正确“挤”痘了吗?啊?你正确“挤”痘了吗?啊?不会挤痘不要随便乱挤痘,这是个有技巧的活好吧,细菌可不是那么好打败的。
第一,你的手无时不刻都有细菌(细菌有引入痘痘的风险!)
第二,你根本不可能把脓挤干净
第三,最怕手残*党**啥都不懂,一顿挤啊。导致脓物不仅向上爆发,还会向下,也就是伤害到我们的真皮层。

怎么办啊!上面丘疹的方法多加一步清除脓物。5.炎症痘痘-囊肿结节:为啥这2个放一块说呢,因为一般囊肿肯定伴有结节,结节肯定伴有囊肿。一样一样滴。它会出现一般是上面的脓疱痘痘没有及时清理感染到了皮下组织化脓坏死,第二个原因是及时清理了,但没有使用正确的清理手法导致的,也就是你们这些“手贱*党**星人”最爱干的事。这个东西的出现,代表着后面即使战争结束,你的脸也不会太“平凡”(会流下痘坑/痘疤)这些难以恢复的后遗症。此处告诫痘肌们,痘痘不要拖,有脓物的痘痘要及时清理。自古以来,随着痘痘的出生,挤不挤它就是一个争议性特!别!大!的问题。没有一定不用挤的痘,也没有一定要挤的痘,自己多学习,不懂就找更专业的人(医生)帮忙,以免造成无法挽回的损伤。怎么办呢?这种呢,日常清洁护肤控油依然要做,但不重要,自己不要碰更不要针清!会引发更严重的囊肿,需要搭配内服药物一起吃,讨厌也没办法,自己作的哭着也要吃下去。囊肿面积过大数量又多的朋友,去医院针抽搭配红蓝光治疗是一个不错的方法。记住,不要拖。日常做好清洁、保湿、控油可以有效的减少痘痘的产生和预防痘痘的加重。-
以下长文瞎眼。请同学们自行对“痘”入座,干掉痘痘君指日可待啊!
1、对付痘痘君,基本的套路(清洁、保湿、控油)要做好,做足功课的同学可自行跳过。温馨提示:略微叨叨,不过,超详细的哟!①日常清洁:我这个把耐操皮zuo成敏感肌还烂脸的人,关于清洁第一句话一定是
氨基酸不是最温和的!
氨基酸不是最温和的!
氨基酸不是最温和的!
自从皂基的出现,大家心理最好的洁面就只剩「氨基酸」系列了!!!
错错错…

发现大家都没有认识到“泡沫多”的危害性。(只要是氨基酸就一定安全!)还在那以为泡沫丰富好!好!玩!呢!
泡沫多!好!冲!洗!呢!
洗面奶不一定要 气泡 ,好的洗面奶可以不起泡。对于痘肌来说:

乳化型洁面>氨基酸洁面
(即使是敏感肌使用,也没在怕的) 洁面能去掉面部多余的油脂和角栓,减少痘痘的滋生并让皮肤更好的吸收护肤品。(不然,不管什么小黑瓶小白瓶都是1X0=0)我们皮肤上的微生物和螨虫是依靠这些为食物来源,而微生物和螨虫正是引发炎症的主要根源。我们分为日常“表面”清洁和定期“深层”清洁。清洁的目的:①去除皮肤上得污垢②温和不损伤皮肤③赋予皮肤有营养的成分。市面上大部分只能满足1 ,因为很多都是皂基类产品(如露得清洗面奶和百雀羚三生花洁面膏)。而氨基酸洁面可以同时满足1跟2 (如芙丽芳丝和elta洁面乳)同时满足3点的是你们最不喜欢的“无泡沫/乳化型”洁面。(注意:对于健康油皮清洁力不够,不推荐。)日常“表面”清洁:早晚洁面,除了油皮,早上尽量清水洁面,晚上洗面奶。已经受损的肌肤(如痘痘肌)和敏感肌最适合的是无泡沫/乳化性的洁面乳,在市面上属于小众产品,现在太多人都追求泡沫感,实际上无泡沫/乳化性的洁面对于皮肤来说才是最温和的,即使是敏感肌使用,也不会伤害的角质层。无泡沫/乳化型洁面乳:

洁面之前一定要先洗手!!!
很多人很奇怪耶!不知道到底是在用脸洗手?还是用手洗脸?
有时还理直气壮给你来一句:我都要洗脸了干嘛还洗手??
那好叭!
注意:不论什么类型的洁面,美白?控油?祛痘?抗氧化?都好。你洁面不到一分钟的时间,我不相信你会去相信这个东西能帮你祛痘…?
不说那么多了,懂的自然懂,该读书读书该吃核桃吃核桃。 ②做好定期深层清洁,角质层过厚也是导致毛囊堵塞的重要原因,记得,做好深层清洁。能有效预防多种皮肤问题的滋生,也能祛除现有的痘痘,对于油皮和痘肌,没什么比刷酸更好的深层清洁产品了。根据中国医师协会发布的《中国人面部皮肤分类与护肤指南》 ,建议油性皮肤2周1次,干皮长痘的黑头的闭口的,记得涂在局部就可以,敏感肌要建立耐受再飘。

国货,比同类产品便宜,成分效果一致没啥好说的
②保湿:长痘的人,屏障本身会被炎症破坏到,水分流失加快,锁水能力下降。水分的缺失会导致你们更容易遭细菌和螨虫的侵袭。所以,保湿很重要。保湿的正确姿势:长痘期间多喝水,因为皮肤水分来源于身体。油痘皮使用清爽型的乳液锁住水分即可。清爽型的乳液:

保湿的错误姿势:疯狂贴面膜,误以为舒缓皮肤。外在的过度补水会导致皮肤屏障受损严重,屏障就像一堵墙,天天泡水会烂的。③控油:还有好多好多的控油姿势!“粉状”(如尼龙粉、硅粉、淀粉)物质的东西也可以吸附油脂。比如:你们可以想象一下面粉是怎么做成面团的~

等等,不要跑去买面粉。。。这里,露西准备好了~说,i 不 i 我!

还有维生素B:维生素B6(呲哆素)和维生素B7(生物素)能够对皮肤的油脂分泌进行控制。还有抗氧化和果酸产品都是控油的好成分。这些产品很多啦,你们可以自己去找。特别特别严重的油脂可以选择口服维生素B2和B6,它们各一次一片一天三次。(口服时间遵医嘱,长期服用对身体有害。)而避免外力因素对皮脂腺的影响,也是一种根源控油手法:长痘期间避免熬夜:熬夜会使身体的雄激素大量分泌,令皮肤出油更旺盛。你们常听到的“熬夜毁脸”现在真相了...长痘期间避免压力:特别是因为“痘痘”的压力,那样就会造成一个死循环。压力越大,痘痘越多,痘痘越多,压力越大。少看镜子,年轻人,心态放好点。长痘期间避免吃太多甜食:甜食会间接的给雄激素打鸡血,刺激皮脂腺分泌更多油脂。长痘期间避免被晒到:不要跟我说你涂了防晒霜,涂够量的防晒霜也只能遮挡60%的紫外线。要求就一个,打伞,尽量打伞。

(非要逼我放出卡车司机才意识到防晒的重要性?)
④长痘期间尽量不要化妆:除非你粉上几层,并随时补妆补妆补妆,不然,你掉妆真的比你素颜还更可怕,坑坑洼洼又有粉,掉得肤色黄一块白一块的。还影响你痘痘的恢复时间。各种粉底液遮瑕膏对遮挡痘痘痘印痘坑有立竿见影效果,但是封闭性会使你的毛孔更缺氧,无疑为皮肤上的细菌和寄生虫制造更多的繁殖条件,让你的痘痘更严重。如果(工作需要),一定要卸干净!因为彩妆产品会加重毛孔的垃圾堆积,排出更难。⑤“人所到之处,都是细菌”注意清洁:很多长痘同学都很理直气壮的跟我说,他!特!别!爱!干!净!

如:“我有洁癖,我每周洗床单洗枕套房间打扫很干净!”“我没有洁癖,但是我注意清洁、没有用手碰痘痘,用洗脸巾洗脸”那我现在问你们一个问题,手机一周清洁几次?我帮你们回答吧,一!次!都!没!有!

手机是很多人极易忽略的一个小细节,之前就有个新闻爆出“手机上的细菌比马桶还脏三倍”很多人表示“好惊讶啊”!!!如我开头所说,本来就是“人所到之处,都是细菌”每天你走到哪里,手机就跟到哪里,你的手上整天碰东碰西,碰完就摸手机,上洗手间也玩手机,上完洗手间擦完PP的手也玩手机。要是没细菌我才奇怪啊好吧!
英国有位学生做了个实验:用培养基(就是给细菌吃的营养物质,吃了细菌会生长繁殖)和手机屏幕接触之后得到的图片↓

大兄die,还拿手机蹭脸不?
解决方法:某宝光速下单手机酒精清洁棉片,一天一次!

⑥痘肌饮食:自古痘痘出生以来,什么能吃什么不能吃简直就是个世界级别的难题,一堆人说海鲜发物不能吃一堆人说海鲜营养能吃,搞得痘痘肌的同学们是啥都不敢吃!吃个东西查这查那,整天担心这担心那。痘痘没去掉,好吃的也没吃到,压力上升,痘痘还更严重了!欧克,露西来了,就不会让这种问题继续困扰痘肌同学们,我们只讲吃什么,不能吃的根本讲不完。长痘的人吃什么痘痘才会越来越少:1.含锌丰富的食物研究表明,锌的不足会导致痘痘加重/产生。人体锌的不足或金属硫蛋白的功能缺陷,对健康会产生影响,其中包括让白血球制造出“发炎”的细胞激素。一般你长痘去医院医生也会给你开锌的健康补充食品。锌的补充能够减缓痘痘的发炎现象,愈合伤口并修复皮肤,还能减轻雄激素对皮肤的影响。食物中含锌最丰富的食物:猪瘦肉、牛肉(瘦)、鱼肉、蚝肉、核桃仁、紫菜、牛奶、鱼类、花生、芝麻、动物肝脏、紫菜、坚果等。蔬菜类:茄子、南瓜、白菜、豆类等亦含有丰富的锌。

也可以从这些补充:

【使用方法】葡萄酸锌片,一天2次,一次3片。2.含不饱和脂肪酸Omega3的食物Omega 3可以抑制细胞激素的活性,而细胞激素的作用是促进体内的发炎反应,因此omega-3可以帮助消炎,还能调节内分泌,可以改善青春痘的症状。食物中含Omega3最丰富的食物:亚麻籽、沙丁鱼、杏仁,核桃、三文鱼、鱼油等。

3.维生素A维生素A可降低皮脂分泌。富含维生素A的食物有:肝脏、贝类。但是吃太多肝脏贝类食物会因为维生素A摄取量过剩导致头晕,关节疼痛等身体不适(孕妇少吃),所以我们可以用β-胡萝卜素来代替,这类食物就多啦,比如甜玉米、芒果、菠菜、哈密瓜、羽衣甘蓝、杏仁干、蛋黄、红椒等。

4.维生素b6维生素B6主要的功能是代谢蛋白质,亦可减缓因生理周期的内分泌不稳定而冒痘的症状,同时对于体内固醇类激素的代谢具有重要的作用,同时也能降低雄性激素对皮肤的影响。富含维生素B6的食物有:全谷类、豆类、坚果类、肝脏、酵母、鱼、蔬菜等新鲜食物。

欧克,以上固定老套路做完基本你就战胜痘痘君一半了!剩下的一半往下看
【走你自己的路,战胜痘痘君!】
1.痘痘分为:无炎症痘痘-黑头/闭口、炎症痘痘-丘疹/脓疱/囊肿结节。1.无炎症痘痘-黑头/闭口:这个上面已经说过解决方法,自行翻。

2.炎症痘痘-丘疹: 这类痘痘主要就是炎症的问题,毛囊堵塞+引起炎症 ,因此消炎抗炎是一个关键。

特点:凸起,红肿、会痛。治疗方法-药物:抗生素药物夫西地酸+第三代A酸阿达帕林/达芙文。

外用抗生素之所以可以用来抗痘,主要是利用抗生素抑制或杀灭*疮痤**丙酸杆菌的作用,也有抗炎作用。但是抗生素药物不能单独使用(不要单独使用夫西地酸!)也不能长时间使用(使用时间不要超过3个月),容易产生耐药性,简单说,就是你用几次,你皮肤适应了后继续再用就不起效了。所以,这里我搭配了阿达帕林,在A酸中属于第三代,也表示它比一二代还要更温和,功效也要略差点,不过,对于红肿痘痘来说足够了,A酸可以溶解粉刺,抗炎还能改善炎症后留下的色素沉着,为你们后期祛痘印省下了不少力气。使用方法:2个药物轮流使用,早上用抗生素药物,晚上用A酸,因为A酸有光敏性。抗生素药物在护肤之后使用,薄涂于患处。A酸可以直接涂抹于患处再护肤,提高药效。A酸在痘痘扁平之后就停止使用。白天使用时选择硬防晒,以防影响功效。如果是没用使用过A酸的同学,初次使用先在额头试用,以防刺激到皮肤。如果你耐受度太低,可以混合跟乳液一起涂抹在脸上,能大大的降低刺激性。治疗方法-护肤品:针对于不耐受/皮肤敏感又有痘痘的同学,也可以使用上水和肌or冰雪吉娜家的果酸精华点涂或全脸涂抹的方式消除红肿痘痘。

•上水和肌,主打成分:壬二酸、无酒精配方,所以跟上面阿达帕林相比,真是相当温和了。•冰雪吉娜,主打成分:果酸是祛痘成分中的温柔派,分子大渗透慢,同时果酸分子上的羟基可以锁水保湿。
使用方法:早晚各一次。
洁面——爽肤——局部点涂凝胶(上水和肌)——乳液保湿
洁面——爽肤——全脸涂抹精华(冰雪吉娜)——乳液保湿
(声明:我跟这些产品之间没有任何的利益关系,不准你们把我想歪!之前推了几次产品就被气得..白头发都要出来了!)

3.炎症痘痘-脓疱:比上面的抗炎消炎还多加了一个“挤不挤”的问题。不针清痘痘自己爆发受损范围会更大更严重。

所有痘痘当中除了“已成熟”的脓疱痘痘需要针清,还有这2种

第一张,冒白头的粉刺,因为里面已经有脓物,继续待下去就是炎症了。第二张,炎症区域的黑头,炎症会蔓延感染。这2者主要是以防它们发展成炎症性痘痘。不建议你们自己针清,毕竟世界上的手残*党**星人还是占大多数的,去医院吧,就几十块钱的事情。针清完之后回家可以敷一张“EGF生长因子”的面膜。表皮生长因子可以加速刚针清完的破损伤口愈合。后期的维稳使用抗生素药物夫西地酸+过氧化苯甲酰。为什么这里我没有说使用阿达帕林呢,因为普遍针清完,痘痘已经扁平,而A酸仅作用于炎症性痘痘上。过氧花苯甲酰的小缺点就是有点刺激,但只要你使用了后,觉得对自己皮肤刺激性不大,就可以放心长期使用,并且是个很好的抗菌药物,外涂到皮肤之后,可以释放出新生态氧和苯甲酰杀死*疮痤**丙酸杆菌,因为*疮痤**杆菌的另一个名字叫“厌氧菌”就是讨厌氧气。

使用方法:上面已经说过抗生素药物不能单独使用。因为过氧苯甲酰不像A酸仅作用于炎症,所以我们可以把抗生素药物和过氧轮着来。今天抗生素药物,明天过氧苯甲酰,也不用避光,但是注意一样选择硬防晒,以防影响功效性。4.炎症痘痘-囊肿结节:轻度囊肿结节的同学忙/不想去医院可以考虑抗生素+过氧化苯甲酰+内服异维A酸一起治疗(如果是女孩子还需要多加一个荷尔蒙治疗)荷尔蒙治疗【原理】:原理是抑制雄性荷尔蒙(女生体内也有雄荷尔蒙),阻止皮脂腺分泌过多的油脂。可以使用女性荷尔蒙、雄性荷尔蒙拮抗剂(如螺内酯)、口服类固醇。简单来说,是这样的


使用方法:外用药物参考上面的脓疱痘痘。A酸和螺内酯的使用方法根据每个人情况的不同,用量和时间长短都不一样,这些都是猛药,遵医嘱,遵医嘱,遵医嘱。
而重度囊肿结节的同学可以去医院做针抽+红蓝光治疗,医生一般也还会搭配点药物一起给你内服治疗更快。(这也是我个人比较推荐的一种治疗方式,安全有效时间短且不折磨人!)针抽治疗【原理】:就是利用针筒扎进囊肿结节的痘痘把脓液给抽出来。把脓液拍完之后,医生会给你进行红蓝光治疗。红蓝光治疗【原理】:首先是蓝光用来祛痘,使用作用于皮肤表层,杀灭*疮痤**丙酸杆菌而起到抗菌消炎的作用,且其还可有效抑制皮脂腺油脂的分泌,防止青春痘的复发。红光是用来祛痘印,穿过皮肤表层组织,作用于瘢痕组织,促使细胞分泌产生胶原蛋白而起到祛除痘印,修复痘疤的作用。像囊肿结节这种重度*疮痤**,一般都需要多做几次,一周可以做1-2次。我们这边价格是30-50左右一次。所以在治疗痘痘的各种手段中,是比较实惠的。注意,正规医院,正规医院,正规医院。以上,该吃药吃药,该找医生找医生。不要过于畏惧医院和排斥自己痘痘,把整个解决原理和过程的都写得这么明白,就是让你们知道,解决痘痘一点都不可怕,这也不是个【绝症】
二、反复长痘的因素(附对应解决方法)
反复长痘的你,最应该先确定的是,你长的真是普通的“痘痘”吗?说出这一个问题,是因为露西从后台接到的私信来看,10个中反复长痘的同学中,就会有一个是“玫瑰*疮痤**”在很多人眼里,脸上长的痘痘都是一样的。但这里面还是有不同的,像“玫瑰*疮痤**”也会长红肿*疮痤**和冒脓的*疮痤**,虽然“玫瑰*疮痤**”跟痘痘有不同点,比如干燥脱屑、灼烧感、有红斑之类的,但是很多人还是依然分辨不出来。所以这类人群,单纯使用痘痘的方法来治疗“玫瑰*疮痤**”,当然去不掉啦。怀疑自己是*疮痤**还是玫瑰*疮痤**?靠着自己瞎猜是猜不到的,最简单的方法还是去找下医生蜀黍麻溜点~~
不可以跳过这一段哦,不无聊不枯燥的,好好看!
【内在因素:需要去医院看医生蜀黍系列↓】

不要觉得无聊都是科普,就不看,如果你真的是个反复长痘的人,就认认真真看完这些,因为有可能已经不是单纯的“痘痘”皮肤问题了,已经跟你的身体“健康”有关。不要小看不要小看不要小看好吗!!!①你精神出“问题”了这个我倒是挺有体会的,很多人在长痘期间都以为痘痘很快就会消失,或者在尝试听了某某个朋友、同事或者网上看到某些神医之后,听他们说某种“祛痘神药”特别好用,最后买回来折腾一阵子,还是没好。有时候可能还会更严重。我那段时间整个人的状态就是大半夜躺着床上一边烦着痘痘不会好一边哭,基本都是哭着睡着的。连续一周梦到自己脸部蜕皮,皮肤变得细腻光滑。。。在痘痘期间,越烦越不能烦,因为这种压力会恶循环,也就是说:压力越大,痘痘越严重,痘痘越严重,压力越大然后就陷入了死循环。原理:长期的慢性紧张会刺激肾上腺源性雄激素飙升。给了你痘痘生长的土壤。

解决方法:长痘期间没有到必要时刻,不要照镜子!一照镜子不仅会有想挤痘的念头,还会导致你更加心烦意乱!长痘期间尽量让自己忙起来。对于不顺心的事情就...莫生气莫生气万千随他去~~~②你“生病”了如果你们在痘痘一直好了又长 长了又好又长,那就要去医院进行排查和对症治疗了。特别是一些妹子。注意,这是身体健康的问题,不是单纯的“痘痘”了。希望你们这些“痘肌”者去掉我怎么可能会“生病”这种念头,我只是长了几颗痘痘而已!这种想法千万不要出现!

③身体过于“男性化”人话就是“雄激素”过高,妹子不要以为只有男孩子才会有雄性激素,女孩子也有,有的女孩有手毛脚毛这些就是因为雄激素比较旺盛,还有的妹子是有喉结的,也是雄激素旺盛的表现之一,高雄激素是影响着反复长痘的因素之一,所以,男孩子一般都比女孩子更加“油腻”因为男孩子雄激素更多。原理:高雄激素会刺激你的油脂分泌加重,同时让毛囊过度角化堵塞毛孔。很多女孩子在过了25岁之后还在不断长痘痘,并且长痘的位置下颚、颈部这种,大姨妈也不规律、粉刺多、体毛多、很可能是“多囊卵巢综合症”。出门左拐去找医生蜀黍。④爸妈给你的惊喜已经有预感到的同学,不要太伤心哈哈。 没办法嘛,就跟个胖子喝口水就会胖一样,你个痘痘肌体质的,熬个夜就容易内分泌失调,喝瓶牛奶就致痘,吃块蛋糕就糖含量过高。。。欧克,啊,整理了好几天一篇终于写完了,眼睛一眨,天就黑了。记得点赞+收藏有时间慢慢学习。-以上,祝同学们好运啊!早日战胜痘痘君!我似乎已经看到你们bulingbuling的小脸蛋了~~
